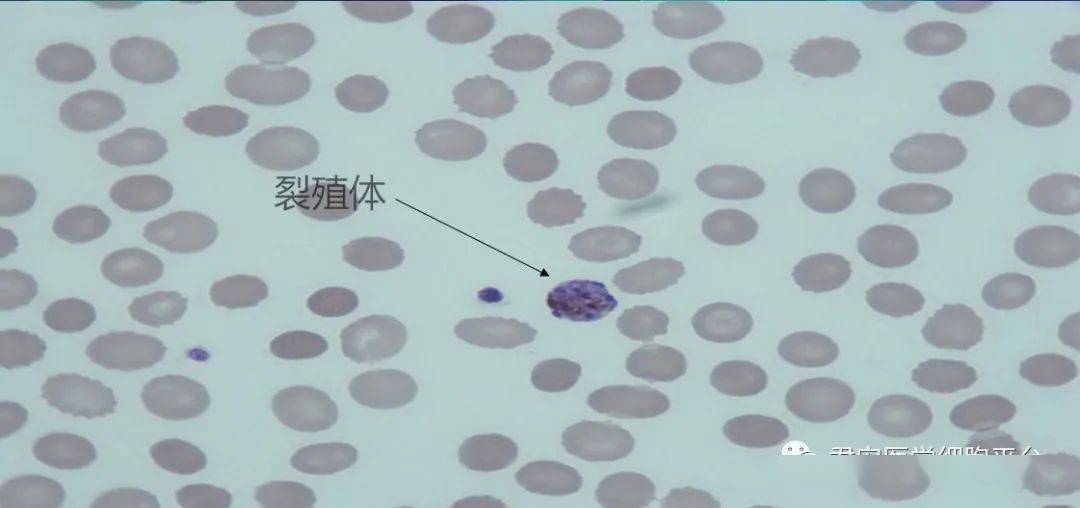
图片讨论顾剑飞老师:在涂片镜检时,发现有白细胞吞噬裂殖体的现象

疟原虫细胞

疟原虫有性阶段雌雄细胞发育(这种有性阶段的疟原虫称为配子体)的调节
图片尺寸399x396
感染疟疾的红细胞
图片尺寸1200x800
血细胞分析仪测定及读片分析疟原虫感染
图片尺寸491x737
看图识细胞第48期疟原虫专场
图片尺寸750x563
血细胞分析仪测定和读片分析疟原虫感染
图片尺寸474x368
疟疾是一种经按蚊叮咬,感染疟原虫所引起的虫媒传染病.
图片尺寸585x492
感染疟疾的红细胞
图片尺寸1200x675
疟原虫血涂片
图片尺寸1080x677
被间日疟原虫感染的红细胞
图片尺寸1200x800
图为疟原虫环状体,滋养体 提示疟疾 part 白细胞形态给我们的反馈
图片尺寸1000x699
寄生在红细胞中的疟原虫,有3期6形:1.滋养体期:小滋养体,大滋养体2.
图片尺寸1362x752
这幅图片展示了红细胞,其中一些被环状体阶段的疟原虫感染.
图片尺寸600x554
图片讨论顾剑飞老师:在涂片镜检时,发现有白细胞吞噬裂殖体的现象
图片尺寸1080x504
近距离观察疟原虫在血红细胞中的背景.
图片尺寸1200x948
双环双核(瑞士-吉姆萨染色)多个较小疟原虫环状体寄生同一红细胞(瑞士
图片尺寸1117x726
疟原虫,红细胞,戏剧表演,滋养体,生物学
图片尺寸1200x675
感染疟疾寄生虫的红细胞
图片尺寸1200x675
看图识细胞第25期疟原虫篇
图片尺寸562x391
图片讨论顾剑飞老师:在涂片镜检时,发现有白细胞吞噬裂殖体的现象
图片尺寸1080x508
人体疟原虫镜下形态及鉴别1
图片尺寸1080x810